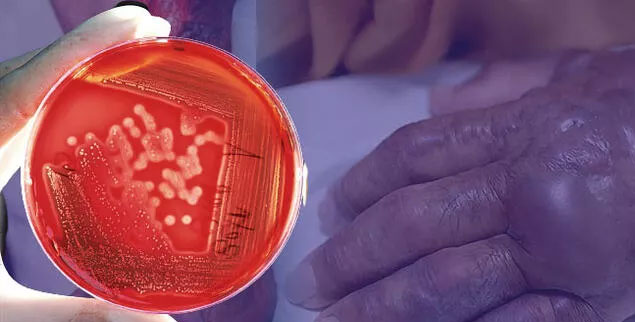
ABD’de korku büyüyor: Et yiyen bakteri vakalarında artış ABD’de korku büyüyor: Et yiyen bakteri vakalarında artış

Et yiyen bakterinin sebep olduğu Vibrio vulnificus hastalığı, ABD’nin Florida eyaletinde artış gösterdi. Özellikle Ian Kasırgası’ndan en çok etkilenen Lee County bu yıl Vibrio vulnificus bakterisi ile enfekte olan 29 onaylanmış vaka ve 4 ölüm gördü. 2020’de hiç vaka görülmeden kentte 2021’de sadece 5 vaka ve 1 ölüm görülmüştü.
IAN KASIRGASI VAKALARI ARTIRDI
Yetkililer, salgının artmasındaki başlıca sebebinin Ian Kasırgası’nın oluşturduğu sel sularına bağlıyor. Sel suları nedeniyle kanalizasyon sularının içme suyu şebekesine karışması bakteri seviyelerini artırdı. Açık yarası ve kesikleri olan kişilerin doğrudan bu bakteriye maruz kalabileceklerine dair yetkililer uyarıyor.
Vibrio vulnificus bakterisi genellikle ılık ve acı sularda bulunur. ABD Hastalık Kontrol ve Önleme Merkezi’ne (CDC) göre, genellikle bir insanın vücuduna çiğ veya az pişmiş istiridye ve kabuklu deniz ürünleri yediklerinde giriyor. Bakteriler ayrıca açık bir yaranın ılık deniz suyuna maruz kalması durumunda cildi enfekte edebiliyor.
ENFEKTE OLAN KİŞİLER KOL VE BACAKLARINI KAYBETTİ
Halk arasında et yiyen bakteri olarak adlandırılan Vibrio vulnificus, açık bir yaranın etrafındaki eti tüketerek nekrotizan fasiite enfeksiyonuna yol açar. Hastalığın ilerlemesi insanların kol ve bacak gibi uzuvlarını kaybetmesine neden olabilir.
Et yiyen bakteriye maruz kalmak kırmızı renkli yaralar, deride şişme, yüksek ateş, nefes darlığı, yüksek kalp hızı gibi belirtilere yok açar. Bu bakteri insandan insana bulaşmıyor.
Açık yaraların kirli sularla temas etmesinin ardından bol su ve sabunla yıkanması tavsiye ediliyor.

 Flipboard
Flipboard